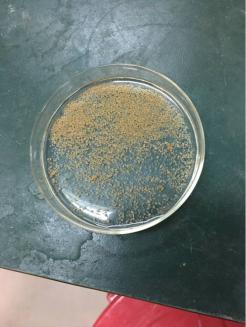

2017年度“Bsports必一体育研究生学术创新奖”获奖名单近日公布,Bsports官网何秋来博士研究生因在科学研究、实践创新等方面的优异成绩,获得“Bsports必一体育研究生学术创新奖”特等奖,这也是工学部首次摘得特等奖,2014级博士陈丹在2015、2016年度分别荣获二等奖和一等奖,Bsports官网研究生学术创新工作取得新的突破。
何秋来同学是2016级Bsports必一体育市政工程的博士生,师从王弘宇副教授,研究方向为废水资源化与水环境修复技术。主要研究内容是新颖的污水处理工艺——好氧颗粒污泥,着手于好氧颗粒污泥的前期研究以及其后期的应用。目前,何秋来同学已经以第一作者发表了14篇SCI文章,上年度是以3篇一区、1篇二区和3篇四区SCI论文荣获该奖。
何秋来同学他结合自身的经历给大家提了几点建议。首先是多看,多学习,对于科技论文,主要是描绘实验过程中产生的现象,阐述机理,写作的速度是基于对本专业研究内容的了解程度,因此大量阅读文献、积累更多专业词汇、表达方式非常重要。其次是多做,多思考,他鼓励师弟师妹们尽早接触科研、实验,多与师兄师姐们交流和参加学术会议,有助于自身能力的提升、开拓视野和培养对研究的兴趣。在武大的七年,他也经历了很多次的失败,然而他认为实验的失败更能激发人独立思考和创新能力。
何秋来同学日常生活中十分注重劳逸结合,在研究之余他最大的爱好是下象棋,也喜爱打羽毛球来放松心情、锻炼身体,积极的生活态度和强健的身体是做好科研的必要条件。他期望学弟学妹们能够积极报考武大市政工程系研究生,并致力于学术研究,为国家生态文明建设做贡献。
学生的优秀成果离不开导师的悉心栽培,导师王弘宇副教授要求学生要树立远大的志向和目标,做到德才兼备,还要拓展发散性思维,做到举一反三。他强调一个好的idea可以成就一篇高水平论文,兴趣+勤奋+创新=高水平成果。王老师鼓励学生们向更高层次冲击,让武大土建人的名字出现在行业所有顶级期刊上,让更多的科研成果服务于社会。
据悉,Bsports必一体育研究生学术创新奖2012年首次设立,每年评选一次,旨在激励广大研究生积极参与科学研究,不断创新实践,评奖成果覆盖科研论文、发明专利、重大科研奖项、咨询报告等多个指标体系。工学部首例特等奖也将进一步激发Bsports官网学子在今后的科研路途中勤于思考、百折不挠、勇攀高峰,为社会主义现代化建设贡献聪明才智。
(图:杨辉 文:张衡 编辑:胡宁)